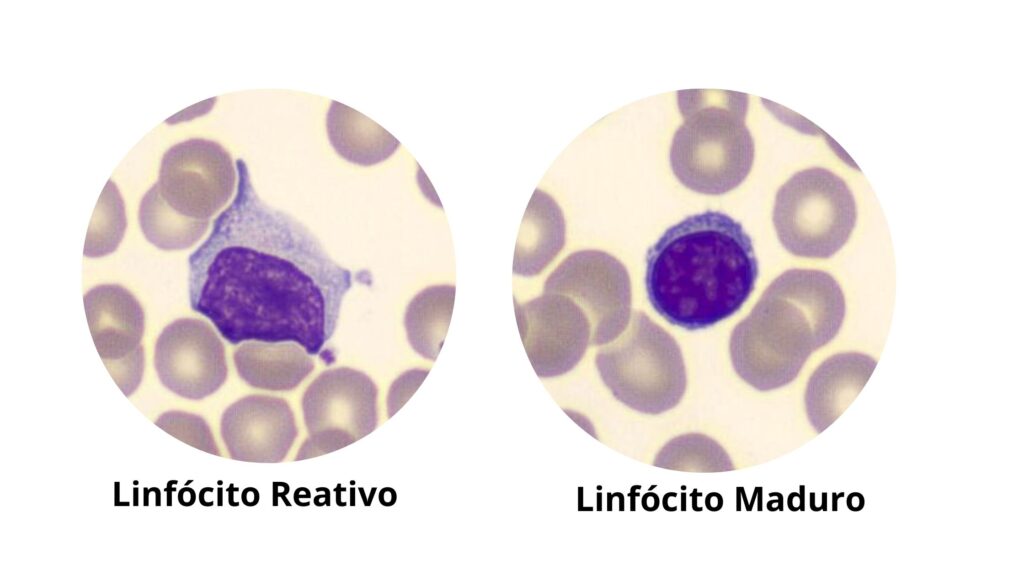

Como Diferenciar células hematológicas é uma das habilidades mais importantes dentro da rotina do laboratório clínico. É também um dos maiores desafios para estudantes, biomédicos, farmacêuticos, biólogos e profissionais das análises clínicas que desejam alcançar segurança diagnóstica, precisão morfológica e capacidade real de interpretar achados no hemograma.
A morfologia hematológica vai muito além de simplesmente reconhecer uma célula ao microscópio. Ela envolve análise criteriosa de características estruturais, maturação, nuances de citoplasma e núcleo, presença de anormalidades, contexto clínico e correlação com os índices hematimétricos.
Apesar disso, existe um método simples, objetivo e aplicável que facilita o processo de identificação morfológica: o método dos 3 passos.
Este artigo detalha cada etapa desse método, explica como aplicá-lo na prática, discute erros comuns e oferece dicas avançadas para quem deseja dominar a leitura de lâminas. Toda explicação é baseada em literatura confiável, boas práticas laboratoriais e na experiência acumulada do dia a dia da rotina hematológica.
Por Que Diferenciar Células Hematológicas é Tão Importante?
A interpretação de lâminas é essencial para:
- identificar alterações infecciosas, inflamatórias, reacionais e neoplásicas;
- reconhecer células imaturas e sinais de atividade medular;
- diferenciar leucemias agudas e crônicas;
- detectar anemias e suas causas morfológicas;
- validar flags críticos do analisador hematológico;
- complementar achados laboratoriais quando o equipamento encontra limitações.
A verdade é simples: quem domina morfologia se torna uma referência dentro do laboratório. Essa habilidade faz diferença em decisões clínicas e na qualidade do laudo, impactando a segurança do paciente.
Método dos 3 Passos Como Diferenciar Células Hematológicas
Agora vamos ao método prático que você pode aplicar imediatamente no laboratório ou nos seus estudos.
1. PASSO 1 – Analisar o Padrão Geral da Lâmina
Antes de focar em uma célula específica, o primeiro passo é observar o conjunto. Essa visão global permite identificar tendências e direcionar o raciocínio morfológico. É como avaliar o cenário antes de analisar os detalhes.
O que observar no padrão geral:
1.1 Distribuição das células
- Estão bem distribuídas?
- Existe aglomeração?
- Há áreas com muita sobreposição?
- O corante foi bem fixado?
Isso impacta diretamente na leitura e pode indicar erros de confecção do esfregaço.
1.2 Tonalidade da lâmina
Uma tonalidade muito azulada ou muito rósea altera a percepção das estruturas celulares.
Exemplo:
- Lâmina azulada → excesso de corante.
- Lâmina rósea → lavagem excessiva.
1.3 Presença de padrões atípicos
Antes de identificar células específicas, você já pode notar:
- anisocitose, poiquilocitose, policromasia;
- presença de células imaturas;
- linfócitos atípicos;
- alterações nucleares que chamam atenção;
- grumos plaquetários;
- áreas com hemácias fragmentadas.
Essa visão inicial define o contexto morfológico.
Por que esse passo importa?
Porque profissionais iniciantes cometem o erro de “caçar” células isoladas antes de entender o cenário.
E a morfologia é contexto.
2. PASSO 2 – Identificar as Características Básicas da Célula
Agora que você conhece o cenário, é hora de focar na célula. Aqui, começamos pela análise de três elementos fundamentais:
- Núcleo
- Citoplasma
- Tamanho da célula
Esses três parâmetros são suficientes para a maior parte das identificações.
2.1 Análise do Núcleo
O núcleo é o melhor ponto de partida porque é onde se encontra a maior variação entre células hematológicas.
O que observar:
a) Formato
- Redondo
- Oval
- Irregular
- Lobulado
- Bissegmentado
- Polilobulado
b) Cromatina
- Fina
- Média
- Grumosa
- Condensada
- Em “rede”
c) Presença de nucléolos
- Blastos geralmente possuem nucléolos visíveis
- Células maduras NÃO devem apresentar nucléolos
d) Relação núcleo/citoplasma (N/C)
- Alta N/C → células imaturas
- Baixa N/C → células maduras
Exemplos práticos:
- Linfócitos reativos → núcleo irregular e bordas “abraçando” hemácias
- Neutrófilos → núcleo multilobulado
- Blastos → núcleo grande, cromatina fina e nucléolos perceptíveis
2.2 Análise do Citoplasma
O citoplasma varia intensamente entre linhagens e estágios de maturação.
O que observar:
a) Cor
- Basofílica (azulada)
- Acidófila (rosada)
- Pálida
b) Granulações
- Ausentes
- Finas
- Grossas
- Tóxicas (neutrófilos)
- Anômalas
c) Bordas
- Irregulares
- Bem delimitadas
- Prolongamentos citoplasmáticos
- Contorno abraçando outras células
Exemplos:
- Linfócito reativo → citoplasma basofílico intenso
- Eosinófilo → granulações vermelho-alaranjadas
- Monócito → citoplasma acinzentado, aspecto “em vidro fosco”
2.3 Avaliação do Tamanho da Célula
Comparar com hemácias é o método mais simples.
Classificação prática:
- Pequena: tamanho aproximado ao de um linfócito pequeno (7–10 µm)
- Média: maior que o linfócito, menor que o monócito
- Grande: geralmente células imaturas, plasmócitos e blasts
Exemplos:
- Linfócito maduro → pequeno
- Monócito → grande
- Blasto → grande com alta N/C
3. PASSO 3 – Usar Critérios Avançados de Diferenciação
Depois de dominar núcleo, citoplasma e tamanho, avançamos para características que fecham o diagnóstico morfológico.
Critérios avançados incluem:
3.1 Análise da Granulação
- Neutrófilos com granulação tóxica indicam infecção bacteriana grave
- Eosinófilos têm granulação uniforme
- Basófilos têm granulações densas e roxas que cobrem o núcleo
3.2 Identificação de Alterações Nucleares
- Vacuolização
- Hipogranulação
- Hipossegmentação (anormalidade de Pelger-Huët)
- Hipersegmentação
3.3 Correlação com a Série Hematopoética
Entender sua linhagem ajuda a concluir:
- Série mieloide: neutrófilos, eosinófilos, basófilos, monócitos
- Série linfoide: linfócitos B, T e NK
Cada série tem padrões claros de maturação.
3.4 Comparação com Achados do Hemograma
Nunca analise células isoladas.
As principais correlações incluem:
- Leucocitose + neutrófilos jovens → infecção aguda
- Anemia + policromasia → resposta medular
- Trombocitose + eosinofilia → possíveis distúrbios reacionais
- Linfocitose + linfócitos reativos → infecções virais
- Blastemia + flags críticos → suspeita de leucemias agudas
Exemplos de Aplicação do Método dos 3 Passos
Agora vamos demonstrar como o método funciona na prática.
Exemplo 1 — Diferenciando Linfócito Maduro de Linfócito Reativo
Pelo método:
Passo 1: Padrão geral
Tendência a linfocitose? Virais? Inflamatória?
Passo 2: Características básicas
- Linfócito Maduro:
- Pequeno
- Núcleo redondo
- Citoplasma escasso
- Pequeno
- Linfócito Reativo:
- Grande
- Núcleo irregular
- Citoplasma amplo e basofílico
- Grande
Passo 3: Critérios avançados
- Bordas do citoplasma tocando hemácias
- Citoplasma mais escuro na periferia
Resultado: fácil diferenciação.
Exemplo 2 — Blasto x Linfócito Jovem

Um dos erros mais comuns.
Passo 2: Núcleo
- Blasto → cromatina fina, nucléolos
- Linfócito jovem → cromatina mais condensada
Citoplasma
- Blasto → basofílico, homogêneo
- Linfócito jovem → menos basofílico
Tamanho
- Blasto quase sempre maior
Exemplo 3 — Monócito x Linfócito Grande

Tamanho
- Ambos grandes
Núcleo
- Monócito → formato em “D”, “rim” ou irregular
- Linfócito grande → geralmente mais arredondado
Citoplasma
- Monócito → fosco e acinzentado
- Linfócito grande → mais vivo e basofílico
Fica fácil após treinar.
Erros Comuns na Diferenciação de Células Hematológicas
- Olhar apenas para o núcleo
A célula é um conjunto, não um fragmento. - Confundir blastos com linfócitos reativos
Acontece por falta de treino em cromatina. - Ignorar correlação com hemograma
A morfologia nunca é isolada. - Treinar com lâminas de baixa qualidade
Isso distorce padrões e atrapalha o aprendizado. - Pular direto para critérios avançados
Sem dominar o básico, nada funciona.
Dicas Avançadas Para Dominar a Morfologia
- Sempre compare a célula com uma hemácia para avaliar tamanho.
- Aprenda primeiro as células normais. Depois avance para atípicas.
- Observe cromatina de forma intencional: é a chave da maturidade.
- Pratique diariamente, mesmo com poucas lâminas.
- Treine em sequência: hemácias → leucócitos → plaquetas → achados especiais.
- Use técnicas de “comparação lado a lado”: blastos x linfócitos, eosinófilos x neutrófilos, etc.
Conclusão
Diferenciar células hematológicas não precisa ser algo complicado.
Com o método dos 3 passos — observar o padrão geral, analisar características básicas e aplicar critérios avançados — qualquer profissional pode desenvolver segurança, agilidade e precisão na leitura de lâminas.
A prática é a verdadeira chave. Quanto mais células você vê, mais seu olho clínico se desenvolve.
Assista a aula completa Como Diferenciar as Células hematológicas em 3 passos
Até a próxima
Sobre o Autor
0 Comentários